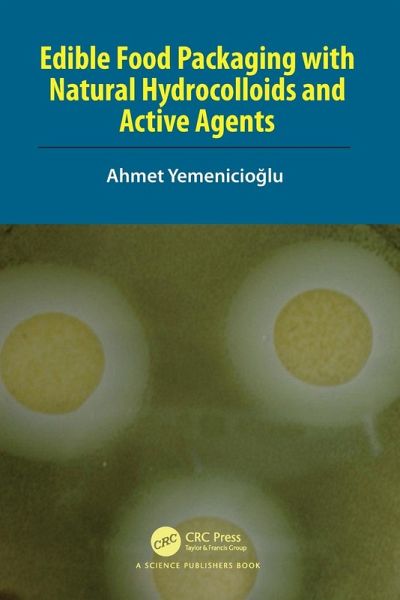

Edible Food Packaging with Natural Hydrocolloids and Active Agents
Versandkostenfrei!
Versandfertig in 1-2 Wochen
98,99 €
inkl. MwSt.
PAYBACK Punkte
49 °P sammeln!
The book provides readers with state-of-the-art developments in antimicrobial, antioxidant and bioactive packaging based on natural hydrocolloids and active agents.